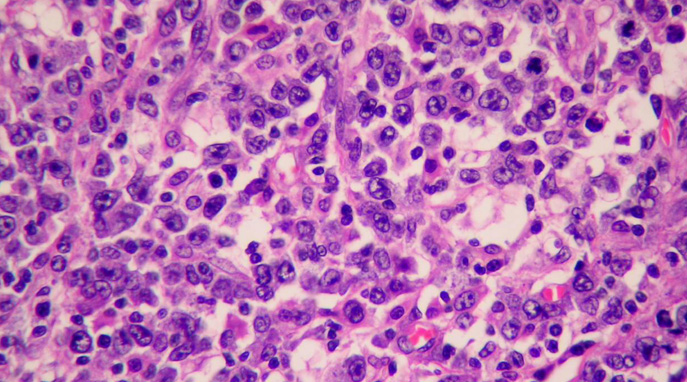

Células genéticamente modificadas parecen ser capaces de erradicar linfoma no Hodgkin en conjunto con una quimioterapia efectiva.
En esta terapia experimental desarrollada en Seattle, se extrajeron glóbulos blancos
conocidos como células T del torrente sanguíneo del paciente.Entonces, se modificaron genéticamente para que puedan detectar y atacar a las células B cancerosas, otro tipo de glóbulo blanco en donde ocurren la mayoría de los tipos de linfoma no Hodgkin.
Un tercio de los 32 pacientes tratados con las células T modificadas experimentaron una remisión completa de su linfoma no Hodgkin. Y a los que recibieron un tratamiento previo con una quimioterapia más agresiva les fue incluso mejor, informan los investigadores.
«Es un fantástico adelanto», afirmó Susanna Greer, directora de investigación clínica e inmunología de la Sociedad Americana Contra El Cáncer (American Cancer Society). «Lograr avances en el linfoma ha sido difícil, en particular en el linfoma no Hodgkin”.
El ensayo clínico también evaluó el tipo de quimioterapia necesario para ayudar a que las células T funcionen con mayor efectividad. Los pacientes recibieron quimioterapia para reducir la cantidad de células B cancerosas y otras células inmunitarias en el organismo, lo que ayuda a las células T genéticamente modificadas a multiplicarse más y a sobrevivir más tiempo.
En el ensayo, un grupo de 20 pacientes que recibió una quimioterapia agresiva con dos fármacos respondió muy bien a la inmunoterapia con células T, y la mitad logró una remisión completa. Los otros 12 pacientes recibieron una quimioterapia menos agresiva, y solo uno entró en remisión completa, apuntaron los investigadores.
Los pacientes que reciben esa inmunoterapia en general se enfrentan a dos tipos de efectos secundarios graves, señaló Turtle. Pueden desarrollar el síndrome de liberación de citocinas, una respuesta inflamatoria sistémica grave que provoca fiebres altas y otros efectos secundarios. O pueden sufrir problemas neurológicos a corto plazo que resulten en temblores, problemas del habla y otros síntomas.
En este ensayo, los investigadores creen que encontraron un grupo de «biomarcadores» sanguíneos que indican si un paciente estaría en un riesgo alto de esos efectos secundarios. Esos marcadores pueden utilizarse para modificar la dosis de células T de esos pacientes.
Si es así, sería otro importante avance a partir de este estudio, afirmó Greer.
«Si pudiéramos identificar biomarcadores asociados con este grupo de pacientes que tienen toxicidades graves, permitiría que los pacientes en riesgo alto participen en esos ensayos clínicos», planteó.
El ensayo clínico continúa, dijo Turtle. «Seguimos tratando a los pacientes, y observamos investigación adicional», comentó.
Los resultados aparecen en la edición del 8 de septiembre de la revista Science Translational Medicine.